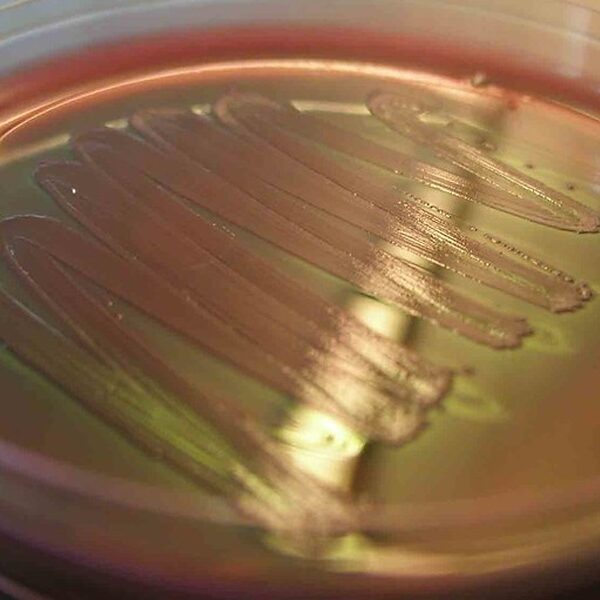
backup_image

Plutonium and its derivatives occupy a unique place in chemistry, where complex electronic structure, radioactivity and environmental behavior all intersect. A concise, organized list helps make sense of the many forms plutonium takes and why they matter for materials science, nuclear fuel cycles and remediation.
There are 29 Plutonium Compounds, ranging from Hydrated plutonium dioxide to Plutonyl(VI) ion (plutonyl). For each entry you’ll find below the columns Formula,Oxidation state,Appearance & stability.
Which oxidation states appear most often among these compounds?
Plutonium commonly shows multiple oxidation states in compounds, especially +3, +4, +5 and +6; +4 and +3 are frequent in solid oxides and hydroxides, while +5 and +6 appear in aqueous species like the plutonyl ion. Expect notes on how redox conditions and ligands shift stability and transform one state to another.
What basic safety or handling considerations are relevant for these species?
Because plutonium is radioactive and chemically toxic, handling prioritizes containment, minimizing dust or aerosol formation, and shielding; chemical form matters (soluble species pose different risks than insoluble oxides), so labs rely on gloveboxes, controlled ventilation, strict waste protocols and radiation monitoring to manage exposure.
Plutonium Compounds
| Name | Formula | Oxidation state | Appearance & stability |
|---|---|---|---|
| Plutonium dioxide | PuO2 | +4 | Black-green crystalline; highly stable, refractory |
| Plutonium(III) oxide | Pu2O3 | +3 | Dark brown-red powder; oxidizes to PuO2 slowly |
| Plutonium sesquioxide (mixed oxide) | Pu3O8 | +3/+4 | Brown-black mixed oxide; moderately stable in air |
| Plutonium monoxide | PuO | +2 | Dark crystalline, air-sensitive; oxidizes readily |
| Plutonyl(VI) ion (plutonyl) | PuO2^2+ | +6 | Colorless to pale; stable in oxidizing aqueous solutions |
| Plutonyl(V) ion | PuO2+ | +5 | Yellowish to brown in solution; moderately unstable |
| Plutonium nitrate(IV) | Pu(NO3)4 | +4 | Colorless to pale solutions; hygroscopic crystalline salts |
| Plutonium nitrate(III) | Pu(NO3)3 | +3 | Soluble, pale to colored solutions; less stable than Pu(IV) nitrate |
| Plutonium tetrafluoride | PuF4 | +4 | Yellow-green powder; chemically stable, high melting |
| Plutonium hexafluoride | PuF6 | +6 | Yellow, volatile gas; highly reactive and oxidizing |
| Plutonium trifluoride | PuF3 | +3 | Greenish solid; moderately stable ionic solid |
| Plutonium tetrachloride | PuCl4 | +4 | Brown crystalline solid; hydrolyzes in moist air |
| Plutonium trichloride | PuCl3 | +3 | Green to violet crystals; hygroscopic, air‑sensitive |
| Plutonyl chloride (dichloride) | PuO2Cl2 | +6 | Yellow crystalline solid; hydrolyzes on moisture |
| Plutonium hydride | PuH2 | +2 | Dark metallic powder; pyrophoric when finely divided |
| Plutonium nitride | PuN | +3 | Black refractory ceramic; chemically stable at high temperatures |
| Plutonium monocarbide | PuC | +4 | Black refractory solid; high melting point, chemically robust |
| Plutonium sesquisulfide | Pu2S3 | +3 | Dark red‑brown solid; moderately stable under inert atmosphere |
| Plutonium monosulfide | PuS | +2 | Dark, metallic lustre; air‑sensitive, oxidizes over time |
| Plutonium(IV) hydroxide | Pu(OH)4 | +4 | Amorphous white to brown gel; poorly crystalline, precipitates easily |
| Hydrated plutonium dioxide | PuO2·xH2O | +4 | Off‑white to yellowish hydrate; poorly crystalline, slowly dehydrates |
| Plutonium(IV) oxalate | Pu(C2O4)2·nH2O | +4 | Yellow to green crystalline precipitate; sparingly soluble |
| Plutonocene (bis(cyclooctatetraenyl)plutonium) | Pu(C8H8)2 | +4 | Air‑sensitive organometallic solid; dark, thermally sensitive |
| Plutonium cyclopentadienyl (tris) | Pu(C5H5)3 | +3 | Air‑sensitive organometallic; oily or crystalline depending on solvation |
| Plutonium acetylacetonate | Pu(acac)4 | +4 | Colored coordination complex; air‑sensitive solutions |
| Plutonium(IV) sulfate | Pu(SO4)2·nH2O | +4 | Colorless to pale crystalline salt; soluble in water |
| Plutonium(III) carbonate | Pu2(CO3)3·nH2O | +3 | White to pale crystalline solid; moderately soluble, hydrolyzes |
| Plutonium peroxide colloid | PuO2·nH2O (peroxo species) | +4 | White to yellow colloidal precipitate; forms in peroxide treatments |
| Plutonium(III) iodide | PuI3 | +3 | Red crystalline solid; hygroscopic and air‑sensitive |
Images and Descriptions

Plutonium dioxide
Plutonium dioxide is the most common stable plutonium oxide formed on oxidation. It is radioactive and chemically persistent, a primary material in waste and corrosion studies, hazardous if inhaled, and important in nuclear fuel research and environmental monitoring.

Plutonium(III) oxide
Pu2O3 is a lower‑valent oxide that oxidizes to PuO2 on air exposure. Radioactive and chemically reactive, it appears in laboratory and corrosion contexts and is handled under strict controls due to inhalation and ingestion hazards.

Plutonium sesquioxide (mixed oxide)
Pu3O8 is a mixed‑valence oxide commonly formed by aging or oxidation of plutonium materials. It is radioactive and chemically persistent, relevant to storage, environmental samples, and waste characterization; not used commercially due to hazards.

Plutonium monoxide
PuO is a low‑valent monoxide reported in condensed phases and surface chemistry. It is air‑sensitive, oxidizes to higher oxides, and is of academic interest in actinide bonding studies; radiological hazards limit its handling.

Plutonyl(VI) ion (plutonyl)
The plutonyl dication is the characteristic linear Pu(VI) oxo species in solution and salts. It forms nitrates, complexes, and is highly radioactive; its chemistry matters for separations, environmental mobility, and actinide speciation studies.

Plutonyl(V) ion
PuO2+ is the pentavalent plutonyl species occurring in reducing solutions and colloids. It is redox‑active, can disproportionate, and influences plutonium transport in the environment; handling requires radiological controls.

Plutonium nitrate(IV)
Pu(NO3)4 is a common soluble Pu(IV) salt used in research and separations. It is highly radioactive and corrosive, forms complexes and nitrates used in analytical chemistry, and poses inhalation and contamination risks.

Plutonium nitrate(III)
Pu(NO3)3 represents Pu(III) in nitrate form and appears in processed solutions and separations. It is radioactive, prone to oxidation, and managed under controlled wet chemistry for nuclear materials processing.

Plutonium tetrafluoride
PuF4 is a refractory fluoride used historically in fluoride volatility chemistry and as an intermediate in processing. It is radioactive and corrosive with strong fluoride hazards, forming insoluble solids used in separations research.

Plutonium hexafluoride
PuF6 is a volatile molecular hexafluoride used in gas‑phase chemistry and historically explored for isotope separation. It is extremely reactive, toxic, and radioactive; its volatility and reactivity require specialized facilities and strict safety controls.

Plutonium trifluoride
PuF3 is a common Pu(III) halide of interest in materials and separations. It is radioactive, insoluble in water, and handled under radiological protection; it appears in conversion and analytical chemistry contexts.

Plutonium tetrachloride
PuCl4 is a covalent/ionic chloride used in coordination chemistry studies. It hydrolyzes on moisture exposure and is radioactive and corrosive; mainly of academic interest rather than practical applications.

Plutonium trichloride
PuCl3 is a common Pu(III salt used in inorganic and organometallic synthesis. It is radioactive, moisture‑sensitive, and used as a precursor for complex formation and fundamental chemistry studies.

Plutonyl chloride (dichloride)
PuO2Cl2 contains the plutonyl cation and is used in actinide coordination studies. It is radioactive and corrosive, hydrolyzes readily, and is handled in specialized labs for speciation and structural work.

Plutonium hydride
Plutonium dihydride forms on hydrogen uptake by metal. It is pyrophoric, radioactive, and of historical interest for metallurgy; hydrogenation alters mechanical and chemical behavior of plutonium metal.

Plutonium nitride
PuN is a dense, refractory nitride studied as a potential nuclear fuel and in materials research. It is radioactive and chemically stable at temperature, investigated for high‑temperature reactor concepts under strict controls.

Plutonium monocarbide
PuC is a refractory carbide of interest for fuel research and materials science. It is radioactive and chemically stable at high temperatures, studied for advanced fuel concepts though not widely used industrially.

Plutonium sesquisulfide
Pu2S3 is a plutonium(III) sulfide studied for bonding and solid‑state properties. Radioactive and hazardous, it is mainly encountered in research and not in common commercial use.

Plutonium monosulfide
PuS is a binary sulfide with metallic character reported in solid‑state studies. It is radioactive and chemically reactive toward oxygen and moisture; primarily of academic interest.

Plutonium(IV) hydroxide
Pu(OH)4 forms as a gelled Pu(IV precipitate) in aqueous chemistry and environmental contexts. It immobilizes plutonium but is radioactive and hazardous; relevant to waste treatment and environmental fate studies.

Hydrated plutonium dioxide
Hydrated PuO2 phases form in aqueous corrosion and waste contexts. They are radioactive, chemically persistent, and important to environmental transport and storage considerations, often forming colloids that influence mobility.

Plutonium(IV) oxalate
Pu(IV) oxalate is a common intermediate used for plutonium purification and precipitation. Radioactive and handled in controlled facilities, it is an analytical and processing reagent in nuclear chemistry workflows.

Plutonocene (bis(cyclooctatetraenyl)plutonium)
Plutonocene is the actinocene organometallic analogue synthesized for bonding studies. It is radioactive, air‑sensitive, and used only in specialized research to probe f‑electron bonding and organometallic behavior.

Plutonium cyclopentadienyl (tris)
Pu(Cp)3 is a Pu(III) organometallic used in fundamental chemistry experiments. It is radioactive, often moisture‑ and air‑sensitive, and of interest for bonding and electronic structure studies.

Plutonium acetylacetonate
Pu(acac)4 is a Pu(IV) chelate used in spectroscopic and coordination chemistry. It is radioactive and handled in controlled labs for structural and reactivity investigations.

Plutonium(IV) sulfate
Pu(IV) sulfate occurs in solution processing and analytical chemistry. Radioactive and corrosive, it is relevant to separation chemistry and environmental behavior of dissolved plutonium species.

Plutonium(III) carbonate
Pu(III) carbonates form under alkaline, reducing conditions and in lab precipitations. Radioactive and chemically reactive with acids, they influence sequestration and solubility in environmental systems.

Plutonium peroxide colloid
Peroxo and colloidal plutonium species form during chemical treatments and oxidation. They are radioactive, mobile as colloids, and important to remediation and waste‑treatment considerations.

Plutonium(III) iodide
PuI3 is a Pu(III) halide used as a precursor in synthetic and materials chemistry. It is radioactive and handled under strict controls; mainly of academic and preparative interest.